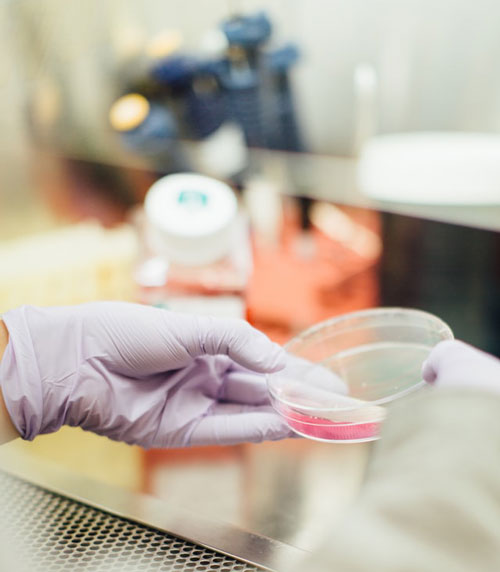
immune-sys-image1

SCIENTIFIC PRINCIPLES
BioPhoton-X™ captures, retains, and radiates electromagnetic energy, in the form of photons, that leads to photolysis of water molecules, and acts as a catalyst for the creation of low levels of free radicals (Reactive Oxygen Species or ROS) such as superoxide, Hydrogen Peroxide, and the hydroxyl radical, which attack and act as oxidizers on organisms such as bacteria.
The reaction of organisms to free radicals is to produce enzymatic and non-enzymatic detoxifying/antioxidants to maintain redox homeostasis.
In higher organisms, such as plants, adult insects, marine species, mammals, and humans, when exposed to moderate levels of increased ROS, leads to levels of production of Superoxide Dismutase, Catalase, and Peroxidase that not only returns the organism to a state of redox homeostasis, but provides an excess of antioxidants that perform additional oxidative stress reduction functions. It is common medical knowledge that antioxidants are essential in maintaining a strong immune system.
The scientific principles previously mentioned have been exposed in many Engeenuity applications, ranging from poultry farming, to agriculture, and in more specific health applications, like Malaria and Immunology.
“Our immune system is highly dependent on the nutrients in our blood stream, and our blood stream is made mostly of water…”
-Susan Samueli Integrative Health Institute
Bone Marrow Transplant Immunology Test
Mice were divided into 4 different groups, the first two groups with 3 mice each, one group receiving no treatment, while the other received regular treatment. The other two groups, composed of 5 mice each, were exposed to two different BioPhoton-X™ treatments to determine the best configuration to optimize immune response.
Each group was analyzed based on the score of each individual mouse, weight loss was based on the percentage of starting weight and testing for significance was done using two-way ANOVA. The characteristics considered were weight loss, systemic score, corneal sensation, fluorescent staining, tear fluid production, MGD Score, and survival.
The summary of results was divided by characteristics, analyzing the four groups in each category. In regard to weight loss, the group which received standard treatment had the highest mean weight loss percentage of all groups; in the corneal sensation category, the group which received standard treatment had the lowest mean of all groups; in tear fluid production,
the group which received standard treatment had the lowest mean among the groups; in the MGD score, which refers to Meibomian Gland Dysfunction, the group which received standard treatment had the highest mean score; finally, in the survival category, the group of mice which received standard treatment presented the worst survival rates.
Although these results are not conclusive and would need to be repeated and improved, we were able to analyze positive tendencies that show there is a possible capacity to improve immune response in one of the most challenging applications, bone marrow transplants. Based on these results, Engeenuity will look to further develop Research & Development in our Life Sciences division.





